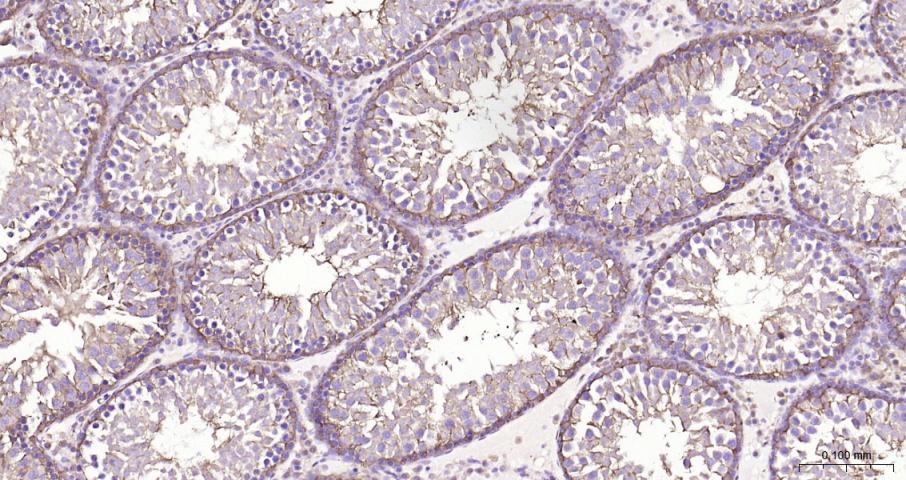
乳酸脱氢酶重组兔单抗

乳酸脱氢酶重组兔单抗
Rrmab?兔单抗

货号:bsm-62875R
产品详情
相关标记
相关产品
相关文献
常见问题
概述
产品编号
bsm-62875R
产品类型
重组兔单抗、mIHC精品抗体
英文名称
LDHA Recombinant Rabbit mAb
中文名称
乳酸脱氢酶重组兔单抗
英文别名
GSD11; HEL-S-133P; LDHM; PIG19; Ldh1; l7R2; CDK1; LDHA_HUMAN; LDHA; LDH-A; Cell proliferation-inducing gene 19 protein; LDH muscle subunit (LDH-M); Renal carcinoma antigen NY-REN-59; 1.1.1.27; LDHA_MOUSE; Ldh-1; LDHA_RAT;
抗体来源
Rabbit
免疫原
A synthesized peptide derived from human LDHA: 254-300
亚型
IgG
性状
Liquid
纯化方法
affinity purified by Protein A
克隆类型
Recombinant
克隆号
18A13
理论分子量
37 kDa
检测分子量
37 kDa
储存液
0.01M TBS (pH7.4) with 1% BSA, 0.02% Proclin300 and 50% Glycerol.
研究领域
Cancer > Cancer Metabolism > Metabolic signaling pathway > Metabolism of carbohydrates
Kits/ Lysates/ Other > Kits > Cell Metabolism Kits > Dehydrogenase Kits
Kits/ Lysates/ Other > Kits > Cell Metabolism Kits > Oxidative Stress Assay Kits > NADP/NADPH
Metabolism > Pathways and Processes > Metabolic signaling pathways > Carbohydrate metabolism
Metabolism > Pathways and Processes > Metabolic signaling pathways > Energy transfer pathways > Energy Metabolism
SWISS
Gene ID
保存条件
Store at 4℃ for short term. Store at -20℃ for long term. Avoid repeated freeze/thaw cycles.
注意事项
This product as supplied is intended for research use only, not for use in human, therapeutic or diagnostic applications.
数据库链接
产品介绍
乳酸脱氢酶(LD)广泛存在于人体各组织中,以肝、肾、心肌、骨骼肌、胰腺和肺中最多。
背景资料
Interconverts simultaneously and stereospecifically pyruvate and lactate with concomitant interconversion of NADH and NAD+.

产品应用
| 应用 | 已检合格种属 | 预测种属 | 推荐稀释比例 |
|---|---|---|---|
| WB | Human, Mouse, Rat | 1:500-2000 | |
| IHC-P | Human, Mouse, Rat | 1:50-200 | |
| IHC-F | Human, Mouse, Rat | 1:50-200 | |
| IF | Human, Mouse, Rat | 1:50-200 | |
| Flow-Cyt | Human, Mouse, Rat | 1:50-100 | |
| ICC/IF | Human, Mouse, Rat | 1:50-200 | |
| IP | Human, Mouse, Rat | 1:20-50 |
交叉反应
交叉反应: Human, Mouse, Rat
相关产品
暂无相关产品
靶标
基因名
LDHA
蛋白名
L-lactate dehydrogenase A chain
亚基
Homotetramer.
亚细胞定位
Cytoplasm.
翻译后修饰
ISGylated.
疾病
Glycogen storage disease 11 (GSD11) [MIM:612933]: A metabolic disorder that results in exertional myoglobinuria, pain, cramps and easy fatigue. Note=The disease is caused by mutations affecting the gene represented in this entry.
相似性
Belongs to the LDH/MDH superfamily. LDH family.
标记抗体
暂无标记数据
同靶标产品
暂无同靶标产品
相关文献
提示: 发表研究结果有使用 bsm-62875R 时请让我们知道,以便我们可以引用参考文章。作为回馈,资料提供者将获得我们送上的小礼品。
暂无相关文献
常见问题
暂无常见问题